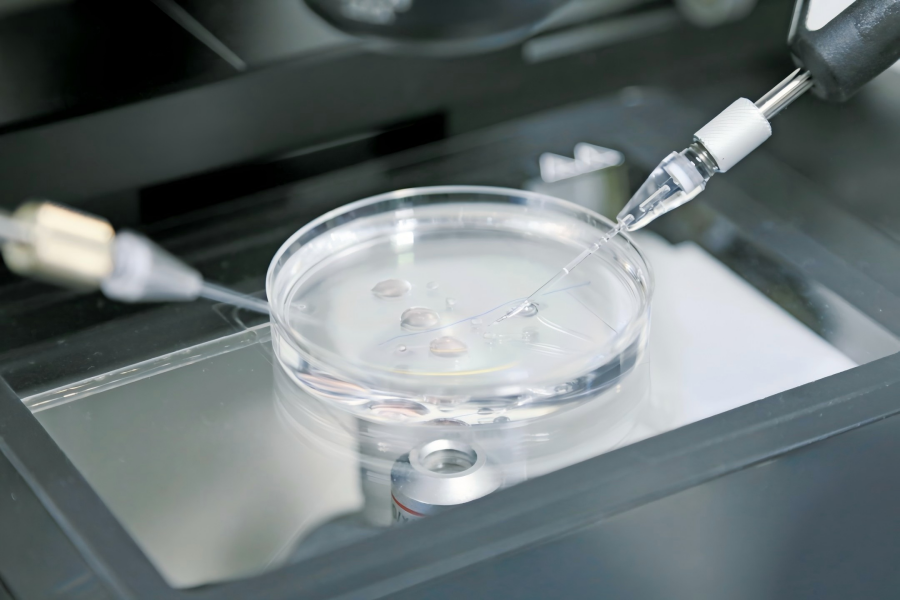

科技现代化是开创云南发展新局面的核心支撑。2025年末,《中共云南省委关于制定云南省国民经济和社会发展第十五个五年规划的建议》提出,要深入实施科教兴滇、人才强滇、创新驱动发展战略,以科技赋能行动为牵引,突出创新对新质生产力的主导作用,以高质量科技供给支撑高质量发展。近日,云南省科学技术厅党组书记、厅长高俊就“强化科技引领赋能,加快创新型云南建设”重点任务给出解答。

大理经济技术开发区内的大理华晟新能源科技有限公司生产车间(资料图)。吴沛钊 摄
“三个一” 锚定创新发展方向
高俊将面向“十五五”,创新型云南建设的核心战略导向概括为“一个根本遵循、一条鲜明主线、一个总体目标”。
“一个根本遵循”,就是要深化落实“越是欠发达地区,越需要实施创新驱动发展战略”的重要要求,坚持“顶天”与“立地”并重,“顶天”即主动服务和融入国家发展战略,发挥自身区位和资源禀赋优势,强化科技创新支撑,攻克一批“卡脖子”技术;“立地”即紧紧围绕一体推进“三大经济”,以科技创新为引领,加快构建具有云南特色优势的现代化产业体系。

2025腾冲科学家论坛在腾冲科学会堂开幕(2025年12月6日摄)。
“一条鲜明主线”,一是扎实推动科技创新与产业创新深度融合。完善以需求为导向的科技项目遴选机制,依托腾冲科学家论坛、彩云汇科创大赛等平台,批量招引优质科技成果入滇落地;打通成果转化中间环节,推动“职务科技成果单列管理”“先使用成果后付费”等改革,构建全链条服务平台;优化成果转化政策服务,加大成果转化落地奖补力度,强化金融赋能,加强技术经纪(管理)人队伍建设,让更多创新种子在云岭大地开花结果。
“一个总体目标”,是奋力建设面向南亚东南亚科技创新中心,立足资源与产业基础,在稀贵金属材料研发、绿色能源与先进制造融合、战略性矿产资源高值化利用、“滇系”种业开发、特色生物资源开发等方面锻造科技长板,加快形成具有全国影响力和核心竞争力的技术创新策源地。同时,深化与南亚东南亚国家在农业科技、卫生健康、数字技术、新能源等领域的合作,打造区域性技术转移枢纽和科技人文交流中心。

云南种子种业联合实验室云南省农业科学院育种共享基地(资料图)。
科技创新筑牢发展根基
高俊表示,“十四五”以来,云南省科技创新之基越筑越实,关键核心技术攻关加速突破,成功开发出高纯铟、铝箔材料、银纳米线材料等一大批高端产品;支持构建较为完整的农业科技创新体系,引育水稻、马铃薯、鲜切花、咖啡等新品种1574个;实施稀贵金属材料基因工程,运用人工智能技术赋能新材料研发,推动滇中稀贵金属集群入围2024年国家先进制造业集群;8个Ⅰ类新药获临床试验默示许可,32个中药大品种销售过亿元。
生物制造实现关键技术突破,在异种器官移植领域,先后开发出单基因到13基因编辑异种器官移植供体猪并实现量产;在干细胞领域,2种细胞Ⅰ类新药获临床批件。
昆明理工大学省部共建非人灵长类生物医学国家重点实验室利用基因编辑灵长类疾病模型解析复杂发病疾病机制(资料图)。金晶 摄
科技引领培育新质生产力
“十五五”时期,云南省将持续提升科技创新能力,因地制宜培育发展具有云南特色的新质生产力,以科技创新引领支撑云南省产业发展。
主动运用新技术改造提升传统优势产业,加大铝、硅、铜、稀土、锡等战略性矿产资源的可持续开发与综合利用,支持高性能铝合金铸造装备、锡铟互连关键材料等重大新产品开发。加大橡胶、甘蔗等农业战略生物资源的挖掘与创新利用,加强高原特色农业新品种选育,大力发展智慧农业。
加快发展战略性新兴产业,深入实施稀贵及有色金属材料基因工程,聚合新材料、生物医药、数字经济、绿色能源等产业的发展资源,因地制宜发展战略性新兴产业集群。加大新药、新型血液制品、药妆等产品的开发力度。
加快前瞻布局未来产业,推动生物制造、干细胞及类器官、异种器官移植等优势研究成果转化应用,深化拓展“人工智能+”,支持低空经济、氢能及新型储能等领域打造一批应用场景,吸引省外科技企业落地。(完)




